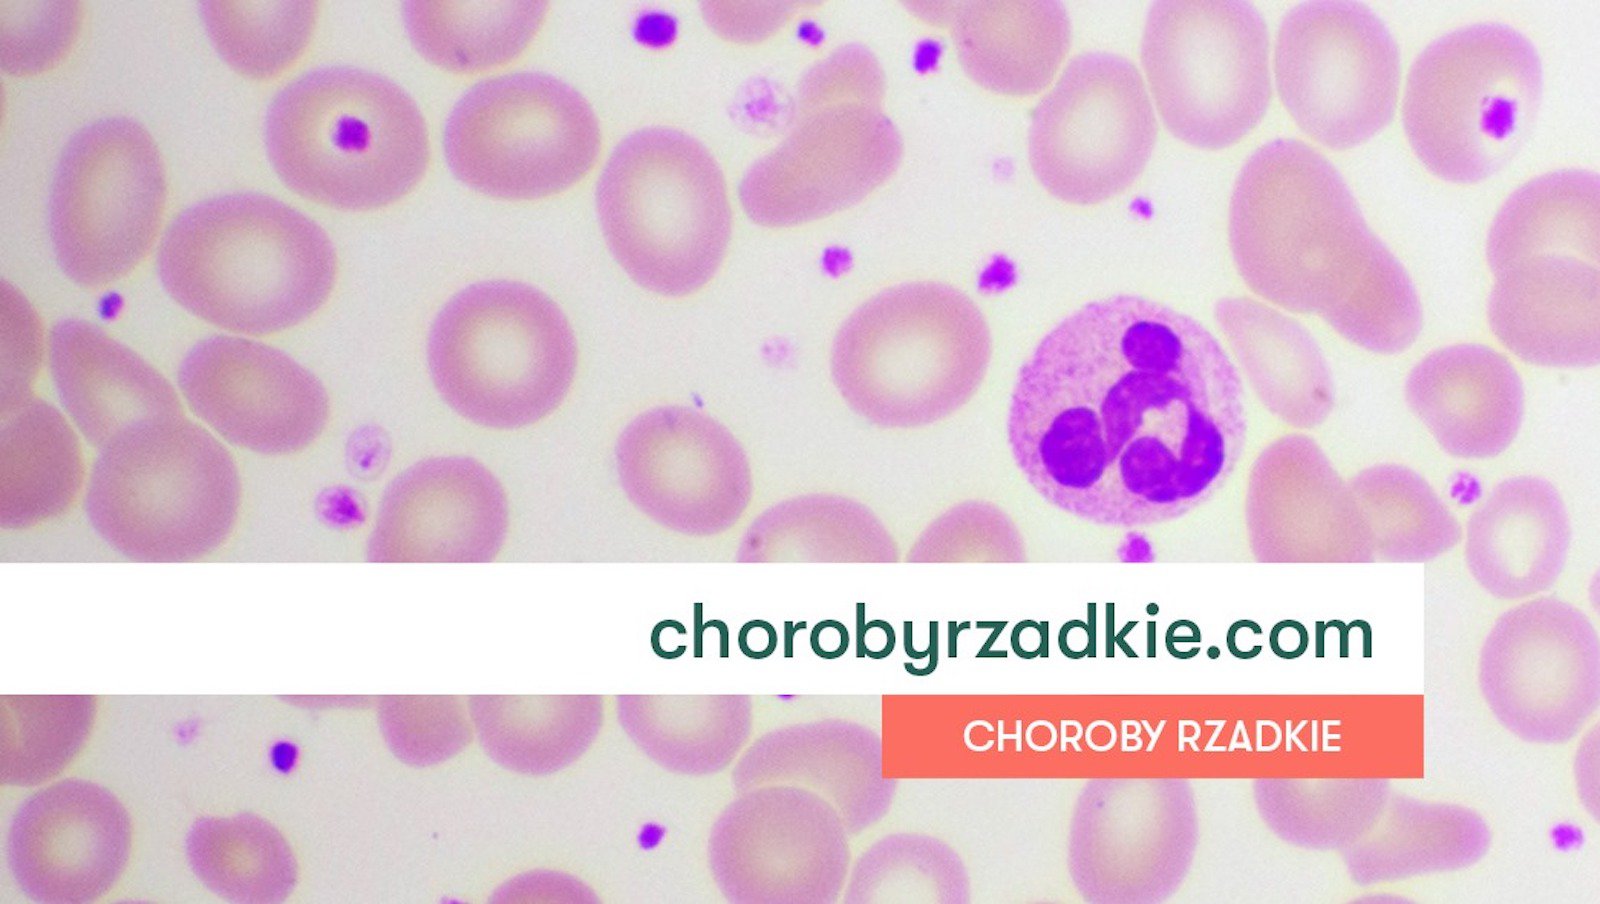
Rusza kampania edukacyjna o chorobach rzadkich

Zdarza się, że w kraju zaledwie kilka osób cierpi na taką chorobę. Pacjenci i ich rodziny czują się przez to osamotnieni. Trudno im znaleźć informacje na temat choroby, właściwego postępowania, niełatwo też zdiagnozować przyczynę cierpienia, bo również wśród lekarzy wiedza na ten temat jest niewystarczająca.
Poprzez publikację edukujemy w zakresie wiedzy dotyczącej chorób rzadkich, przechodząc przez aspekty związane rozpoznaniem choroby, aż do innowacyjnych terapii i dostępie do nich w Polsce. W ramach projektu porozmawiano z przedstawicielami ochrony zdrowia, ekspertami oraz pacjentami dotkniętymi chorobami rzadkimi.
W wydaniu z zakresu hemotoonkologii i hematologii poruszono poniższe tematy:
- Narodowy Plan dla Chorób Rzadkich szansą dla pacjentów
- Porfiria – jak ją rozpoznać i leczyć?
- Choroba Castlemana – czym jest i jak się objawia?
- Ostra białaczka szpikowa – terapia i ścieżka diagnostyczna okiem pacjenta
- Ostra białaczka szpikowa – jaki jest obraz tej choroby?
- Ostra białaczka szpikowa– do jakiego leczenia maja dostęp polscy pacjenci?
- Rzadkie nowotwory złośliwe
Wszystko po to, by budować społeczną świadomość oraz zmieniać sytuację osób chorych na lepsze. Postawiono na rzetelny i sprawdzony przekaz, dlatego treści stanowią wypowiedzi wybitnych specjalistów.![]() Publikację w formacie PDF mogą Państwo pobrać w całości tutaj.
Publikację w formacie PDF mogą Państwo pobrać w całości tutaj.
Źródło: Informacja prasowa